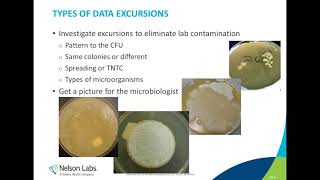
Microbiological Control in a Pharmaceutical Manufacturing Environment

Microorganism Standards
Enroll to start learning
You’ve not yet enrolled in this course. Please enroll for free to listen to audio lessons, classroom podcasts and take practice test.
Interactive Audio Lesson
Listen to a student-teacher conversation explaining the topic in a relatable way.
Understanding Water Microorganism Standards
🔒 Unlock Audio Lesson
Sign up and enroll to listen to this audio lesson

Today, we're discussing microorganism standards, particularly in water quality. Can anyone tell me what these standards are?

Isn't it something like '5 microorganisms per 100 ml' for water?

Exactly! The CPCB recommends a maximum of 5 pathogenic microorganisms per 100 ml of water. Why is it so important to monitor these pathogens?

Because they can cause serious health issues, right?

Correct! Bacteria are the main focus here, but we also need to be aware that viruses and fungi might be present. Monitoring is crucial for ensuring safe drinking water.

What about the monitoring methods? How do we actually count these tiny microorganisms?

Great question! It can be challenging as they are often too small to count directly. We will discuss methods like culturing and flow cytometry shortly.
Counting Microorganisms
🔒 Unlock Audio Lesson
Sign up and enroll to listen to this audio lesson

One traditional method for counting microorganisms involves culturing. Can someone explain how this process works?

You take a water sample and place it on a nutrient medium, right?

Exactly! The sample is incubated, allowing the bacteria to multiply. We refer to the results as Colony Forming Units or CFUs. Why do you think this method might take a full day?

Because it takes time for the bacteria to grow into visible colonies?

Yes! This method is great for detecting viable bacteria. But is it effective for very high concentrations?

Not really. You would have to dilute the sample first!

Correct! Dilution helps us manage high counts, ensuring distinct colonies form.
Alternative Techniques in Microbial Analysis
🔒 Unlock Audio Lesson
Sign up and enroll to listen to this audio lesson

Now let's discuss newer techniques, such as flow cytometry. Can anyone explain what this involves?

I think it counts cells as they pass through a small channel?

Exactly! It counts cells rapidly but raises questions about sample representativeness. Why is that a concern?

If the sample isn’t uniform, we might not get accurate counts?

Right! Accurate analysis requires careful sample preparation. And what about dye-staining methods?

Those help distinguish different types of microorganisms, like bacteria from fungi!

Perfect! Using stains combined with fluorescence microscopy can enhance our understanding of microbial populations.
Practical Challenges in Microbial Analysis
🔒 Unlock Audio Lesson
Sign up and enroll to listen to this audio lesson

What are some challenges we face when analyzing microorganisms?

Isn’t it hard to see very small bacteria?

Definitely! Their small size makes them difficult to count accurately. What signs might indicate a high microbial concentration?

Turbidity in water!

Yes! But remember, turbidity alone doesn’t confirm the presence of harmful microorganisms. We need to apply viable testing methods.

And doing culturing seems to be the best way to ensure they are alive or not!

Exactly! Culturing reveals viable cells, which is crucial when considering health risks associated with pathogens.
Introduction & Overview
Read summaries of the section's main ideas at different levels of detail.
Quick Overview
Standard
The section outlines the importance of assessing microbial quality in water, detailing various methods like culture techniques and flow cytometry. It emphasizes the challenges of counting microorganisms and introduces standards such as those established by the Central Pollution Control Board (CPCB) for bacterial populations.
Detailed
Detailed Summary
In this section, we explore the standards adopted for analyzing microorganisms, particularly pathogens such as bacteria in water quality. The CPCB sets forth specific numerical standards, such as a maximum of 5 microorganisms per 100 ml of water. Bacterial sizes range from 1 to 10 microns, making counting challenging without the aid of microscopes. A common method to quantify these microorganisms involves a culturing technique, where a water sample is placed on a nutrient medium that supports bacterial growth.

After incubation, these microorganisms multiply and form colonies, allowing for easier counting. Colony Forming Units (CFUs) provide a measure of viable bacteria. For higher concentrations, dilution techniques are often necessary to distinguish individual colonies. Alternative techniques such as flow cytometry are gaining traction, although they are not yet standard. Staining methods with dyes aid in differentiating between bacteria and fungi as well. While turbidity can indicate high microbial concentrations, it is not a definitive measure. Ultimately, verifying viable microorganisms through growth in a nutrient medium remains the most reliable method. This has significant implications for public health and environmental quality, as pathogenic microorganisms can cause infections and other health risks.
Youtube Videos

Audio Book
Dive deep into the subject with an immersive audiobook experience.
Microorganism Analysis Standards
Chapter 1 of 8
🔒 Unlock Audio Chapter
Sign up and enroll to access the full audio experience
Chapter Content
So, here if we look at the standards that people use for analysis of microorganisms, for example CPCB standards for microorganisms will be like say 5 per 100 ml or 5 microorganisms for 100 ml. So, the microorganisms we are talking about are predominantly pathogens. Many of the pathogens are bacteria, there are a few viruses and all that but mainly bacteria and for water quality, people count the number of bacteria in it. Here we focus on water only. There are bacteria in air also, fungal spores and all but there are no standards for it yet. It is still going on people are trying to develop it but it will take some time for it to happen.
Detailed Explanation
In analyzing water quality, specific standards are set for microorganism counts. For example, one standard from the Central Pollution Control Board (CPCB) suggests that there should be no more than 5 pathogens per 100 milliliters (ml) of water. These pathogens are primarily bacteria, and they are a concern for water quality. While there are also microorganisms in the air, like bacteria and fungal spores, there are currently no established standards for their analysis. Work is being done to create these standards, but it's still an ongoing process.
Examples & Analogies
Think of it like a classroom setting where a teacher limits the number of students allowed per group for a project. Just as the teacher wouldn’t want too many students in one group because it might get chaotic, water quality standards like this help ensure that there aren’t too many pathogens in the water, keeping it safe for consumption.
Counting Microorganisms
Chapter 2 of 8
🔒 Unlock Audio Chapter
Sign up and enroll to access the full audio experience
Chapter Content
So, how do you count say 5 per 100 ml? This bacteria size is around 1 to 10 microns, it means if I take 100 ml sample, I have to see it, it is difficult to count, so you need a microscope. So how do you do this? You take 100 ml of sample you filter it put it on a filter paper and observe the filter paper if somewhere in the filter paper there are 5-micron spots. Filter papers are big 2.5 centimeters in size, you have to search for 5 microns somewhere, so, it is not very easy.
Detailed Explanation
Counting microorganisms in a water sample is a challenging task due to their small size. For instance, if a microorganism's size ranges from 1 to 10 microns, counting them in a 100 ml sample may require sophisticated methods. One primary method involves filtering the sample through filter paper to capture the microorganisms, which can then be examined under a microscope. However, locating and counting the microscopic cells on the filter can be complicated and time-consuming due to their small size compared to the filter paper.
Examples & Analogies
Imagine trying to find a few tiny seeds in a large pile of sand. You know they are there, but spotting them amongst everything else is much harder than you might think. Just like that, finding and counting tiny microorganisms in water requires a careful and methodical approach!
The Culturing Method
Chapter 3 of 8
🔒 Unlock Audio Chapter
Sign up and enroll to access the full audio experience
Chapter Content
So, this is a big challenge, counting microbial populations is a big challenge. One of the old standard methods is that people use what is called as a culturing method. A lot of people work on these various ways of doing it, but one of the simplest methods is to take a water sample and you culture the bacteria on a nutrient medium. Typically, what you do is, you take a plate filled with some nutrients. There are some standard nutrients. Nutrient is something in which the bacteria will grow, uses that as a substrate and it will multiply.
Detailed Explanation
To address the difficulty of counting microorganisms, a common method used is called culturing. This process involves taking a water sample and placing it on a nutrient-rich medium, typically a plate filled with nutrients essential for bacteria to grow. The bacteria in the sample will use these nutrients to multiply, forming visible colonies over time. This method allows for easier counting of microorganisms as it transforms small, invisible cells into larger, countable colonies.
Examples & Analogies
Think of it like planting seeds in soil. At first, you can’t see them, but over time they grow into plants that you can easily count. Similarly, culturing converts tiny bacteria into visible colonies, making them easier to count.
Incubation and Colony Formation
Chapter 4 of 8
🔒 Unlock Audio Chapter
Sign up and enroll to access the full audio experience
Chapter Content
So, what people do is they take say 1 ml of water sample and put it on a nutrient medium. And in the sample say there are 5 bacteria and you cannot see it because it is micron size. And then you incubate it for a day or 24 hours at some temperatures 30 degrees centigrade or 25 degrees centigrade. Then what happens is, they allow the bacteria to multiply. So, the bacteria multiply and it becomes a small cluster, multiply and grow around here. So, when it becomes big you can see it.
Detailed Explanation
After placing the water sample on the nutrient medium, the next step is incubation. This involves keeping the samples at a specific temperature (usually around 25-30 degrees Celsius) for about 24 hours. During this time, any bacteria present in the sample will multiply, forming clusters that eventually grow into visible colonies. This allows for easier observation and counting of the bacteria, which were initially too tiny to see.
Examples & Analogies
It’s similar to baking bread. When you mix yeast (the bacteria) with the dough and let it sit warm, it expands and grows. Just like the dough rises, the bacteria multiply, forming larger clusters (colonies) that can be seen and counted.
Challenges of High Concentration
Chapter 5 of 8
🔒 Unlock Audio Chapter
Sign up and enroll to access the full audio experience
Chapter Content
So, what if it has 100 already? If you have 100, you have no problem because there are other methods of doing it. But if you do culturing when you have a very high concentration, you already have a lot of dots and this at the end of one day, you may get the big jumble, a big mass, and you cannot differentiate how many originally were there. So, usually the analysis prefers that, if you have a very large number, you dilute it so that you can get distinct masses of colony forms.
Detailed Explanation
When counting microorganisms, if the initial concentration is very high, it can lead to complications. After culturing, instead of distinct colonies, you may end up with a big mass of growth where it's hard to identify how many original cells were present. To avoid this, samples with high concentrations are usually diluted. This dilution allows for distinct colonies to form, making it easier to count and estimate the original number of microorganisms.
Examples & Analogies
Imagine pouring too many fruits into a small bowl. They all get squished together and it’s hard to count how many fruits are there. By spreading them out onto a larger plate, you can see each piece more clearly. Similarly, diluting microorganisms allows for easier counting.
Counting Techniques and Technology
Chapter 6 of 8
🔒 Unlock Audio Chapter
Sign up and enroll to access the full audio experience
Chapter Content
So, microbes are treated like particles, so you can also look at it like a particle and look at it in a microscope and there are a lot of instruments now available, which use microscopy in order to count bacterial cells and these are not standard methods, but people use what is called as flow cytometry.
Detailed Explanation
There are advanced techniques for counting microbes that treat them like tiny particles. Flow cytometry is one such method that is gaining traction. This technique involves passing a water sample through a small channel where microorganisms are counted as they flow past a detection point. Although it's not yet widely accepted as a standard method for microbial analysis, it offers an efficient way to count and analyze bacteria quickly.
Examples & Analogies
Think of the flow cytometer like a fast-moving assembly line at a factory where each tiny product (microbe) gets counted as it passes by a sensor. This allows for rapid counting without having to stop and check each item manually.
Staining and Identification Techniques
Chapter 7 of 8
🔒 Unlock Audio Chapter
Sign up and enroll to access the full audio experience
Chapter Content
So, people use other ways of detecting bacteria also which includes putting a dye something called a staining. They put a dye, this dye will go and absorb on different organisms in order to distinguish between which bacteria which fungus it is and then you can use what is called as a fluorescence microscope in order to detect and count.
Detailed Explanation
Other techniques for detecting bacteria include staining, where a dye is applied to the microorganisms. This dye attaches to different organisms, enabling researchers to distinguish between types of bacteria and fungi. After staining, a fluorescence microscope can be used to visualize and count these organisms, as the dye helps highlight them against the background.
Examples & Analogies
It's like coloring a page with different colors to make specific shapes stand out. The dye makes the bacteria visible and easier to count, just like colors help us see the details in a picture more clearly.
Viable vs Non-Viable Microorganisms
Chapter 8 of 8
🔒 Unlock Audio Chapter
Sign up and enroll to access the full audio experience
Chapter Content
In general, if the concentration of microorganisms is very high, it will show up as turbidity. So water is not clear, which means it could be because a lot of bacteria is there so it is a suspended particulate matter; and that’s why there is turbidity. The turbidity is one measure of microorganisms but not always, you cannot be sure. So the only way to make sure that it is a microorganism is to put it on and see if it is growing.
Detailed Explanation
High concentrations of microorganisms in water can lead to turbidity, which means the water appears cloudy. While turbidity can indicate the presence of microorganisms, it is not definitive proof that they are alive or harmful. To assess their viability, a sample must be cultured to see if the microorganisms grow, confirming they are living (viable) rather than dead (non-viable).
Examples & Analogies
Think of a cloudy glass of water; just because it's cloudy doesn't mean it’s dirty or bad to drink. We need to test it further. Similarly, turbidity tells us something might be there, but we need tests to find out if it’s harmful or not by checking if the organisms can grow.
Key Concepts
-
Microbial Standards: Regulations for acceptable levels of microorganisms in water.
-
Culture Method: A common technique used for measuring bacterial populations by growing them on nutrient media.
-
Flow Cytometry: Advanced method for counting and analyzing microorganisms in real-time.
-
Viable vs. Non-Viable: Differentiating living microorganisms from those that are inactive or dead.
-
Turbidity: An indicator of potential microbial presence, observing water clarity.
Examples & Applications
When testing water for E. coli, labs often use a culture method, incubating samples to observe the growth of colonies.
In advanced microbiology labs, flow cytometry allows for rapid counting of live bacterial cells in a water sample, providing immediate results.
Memory Aids
Interactive tools to help you remember key concepts
Rhymes
Five per hundred, keep it right, pathogens in water should not bite.
Stories
Imagine collecting a water sample. You pour it on nutrient agar; if you see colonies the next day, it means the water is not okay!
Memory Tools
ABC - Always Be Counting (microorganisms) to ensure water safety!
Acronyms
TURB - Turbidity Indicates Risk in Bacteria.
Flash Cards
Glossary
- CPCB Standards
Guidelines set by the Central Pollution Control Board for the maximum acceptable levels of microorganisms in water.
- CFU (Colony Forming Unit)
A unit used to estimate the number of viable bacteria or fungal cells in a sample.
- Viable
Refers to living microorganisms that have the potential to grow and reproduce.
- Turbidity
Cloudiness or haziness in water, often caused by suspended particles, including microorganisms.
- Flow Cytometry
A technology used to count and analyze microscopic particles in a fluid as it passes through a laser.
- Incubation
The process of maintaining environmental conditions conducive to the growth of microorganisms.
Reference links
Supplementary resources to enhance your learning experience.
